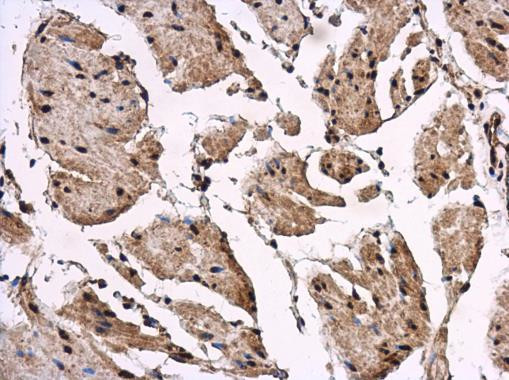
REST Antibody in Immunohistochemistry (Paraffin) (IHC (P))

Search
Invitrogen
REST Polyclonal Antibody
{{$productOrderCtrl.translations['antibody.pdp.commerceCard.promotion.promotions']}}
{{$productOrderCtrl.translations['antibody.pdp.commerceCard.promotion.viewpromo']}}
{{$productOrderCtrl.translations['antibody.pdp.commerceCard.promotion.promocode']}}: {{promo.promoCode}} {{promo.promoTitle}} {{promo.promoDescription}}. {{$productOrderCtrl.translations['antibody.pdp.commerceCard.promotion.learnmore']}}
图: 1 / 4
REST Antibody (PA5-78148) in IHC (P)




产品信息
PA5-78148
种属反应
宿主/亚型
分类
类型
抗原
偶联物
形式
浓度
规格
纯化类型
保存液
内含物
保存条件
运输条件
RRID
产品详细信息
Positive Control: HeLa, HeLa nuclear, U87-MG, U87-MG nuclear extract
Store product as a concentrated solution. Centrifuge briefly prior to opening the vial.
靶标信息
Transcriptional repressor which binds neuron-restrictive silencer element (NRSE) and represses neuronal gene transcription in non-neuronal cells. Restricts the expression of neuronal genes by associating with two distinct corepressors, mSin3 and CoREST, which in turn recruit histone deacetylase to the promoters of REST-regulated genes. Mediates repression by recruiting the BHC complex at RE1/NRSE sites which acts by deacetylating and demethylating specific sites on histones, thereby acting as a chromatin modifier.
仅用于科研。不用于诊断过程。未经明确授权不得转售。
篇参考文献 (0)
生物信息学
蛋白别名: Neural-restrictive silencer factor; neuron restrictive silencer factor; RE1-silencing transcription factor; repressor binding to the X2 box; transcription factor; X2 box repressor
基因别名: DFNA27; GINGF5; HGF5; NRSF; REST; WT6; XBR
UniProt ID: (Human) Q13127
Entrez Gene ID: (Human) 5978